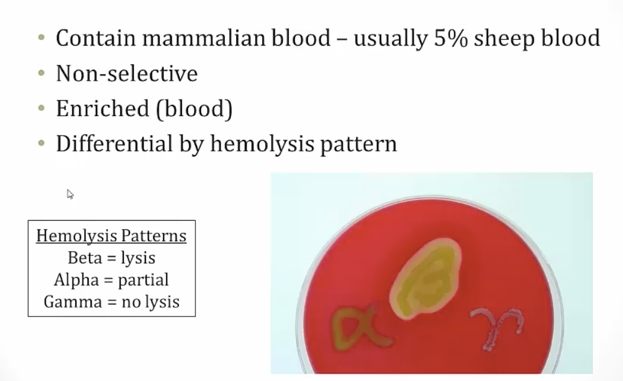
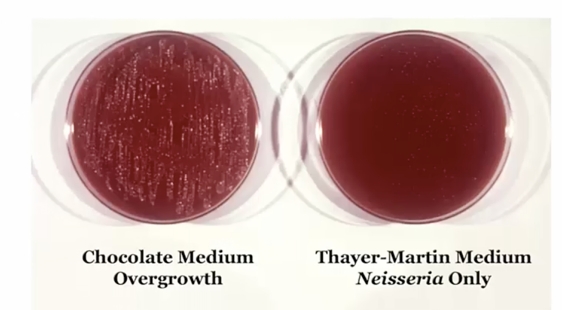
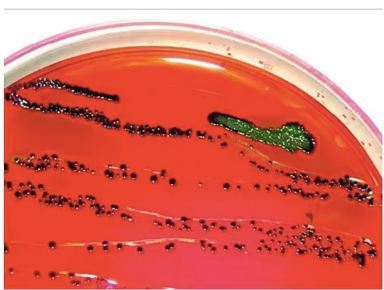
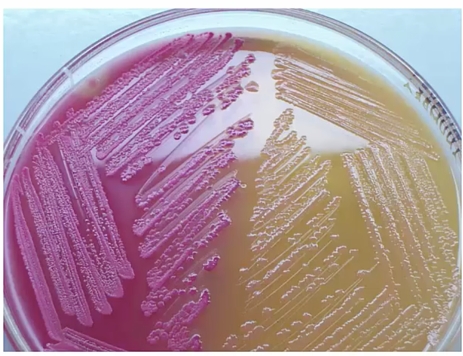

02 Bacteria Culture
Bacterial culture


Fastidious bacteria

Blood Agar

Chocolate Agar


VPN

Bordet-Gengou agar

Loeffler's media
Tellurite plate
Lowenstein-Jensen

Eaton's agar

MacConkey's agar


Eosin-Methylene Blue

Sorbitol MacConkey

Buffered charcoal yeast extract

Sabouraud's agar

Special growth requirements
Superoxide dismutase and catalase

Aerobes

Anaerobes




Intracellular
Last updated